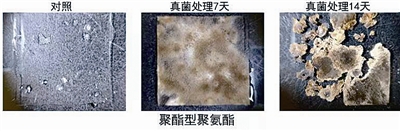

■孙超岷团队成员正在研究“吃”碎片的海洋微生物。
■海洋微生物对聚酯型聚氨酯的降解图示。
□青岛日报/观海新闻记者 李勋祥
仅仅一年时间,深耕海洋微生物研究的中国科学院海洋研究所孙超岷课题组就接连获得两项重大科研进展。“2021年,我们首次发现能有效降解塑料垃圾的海洋微生物菌群。今年,我们再次发现并培养出‘升级版’海洋微生物,不仅能有效降解多种类型塑料,而且降解速率更快,两周内即可将一些塑料降解为碎片。”孙超岷说。
像许多发明一样,塑料本身并不是“坏物质”。不过,大量塑料生产和废弃正对气候变化、自然损失和污染方面造成“三重危机”。海洋所的研究结果,有望突破多种难降解塑料的降解瓶颈,开发出环境友好型降解塑料垃圾生物制品。目前,该成果已申请国家发明专利保护;4月28日,已申请国际发明专利保护,科研成果转化正在推动中。
发现以塑料为“食”的海洋微生物
在中科院海洋所实验海洋生物学重点实验室里,大大小小的透明玻璃瓶里盛着些许“水”“泥土”,排在桌子上、冷藏箱里。孙超岷介绍,这是通过“科学”号科考船等方式获取的第一手海洋沉底物样品,一滴水或者一把泥里面,就有数千万计的海洋微生物。
其实,他们最初并没有特别关注能够降解塑料的海洋微生物。2016年,日本京都工艺纤维大学科学家发表论文,称在陆地上发现了能有效降解聚对苯二甲酸乙二醇酯塑料(PET)的微生物。这给孙超岷团队极大启示:海洋中存在大量塑料垃圾,是否有海洋微生物能够有效降解塑料?
带着这种想法,他们自2016年开始从青岛近海采集了上千份塑料垃圾。“塑料是一类高分子聚合物的统称,聚乙烯(PE)、聚丙烯(PP)、聚苯乙烯(PS)、聚氯乙烯(PVC)、聚氨酯(PUR)及聚对苯二甲酸乙二醇酯(PET)等六种塑料制品是目前塑料垃圾的主要来源。”孙超岷说,通过对收集的塑料垃圾进行大量筛选,他们先后发现了附着在塑料垃圾上的两种海洋微生物。2021年发现的是一种细菌,能有效降解PET和PE两种塑料。今年发现的是一种成长后肉眼可见的真菌,不仅能有效降解当前用量最大、污染最重、最难降解的PE塑料,同时对PP、PS、PVC、PUR、聚酰胺(PA)和生物可降解塑料都有明显的降解效果。
微生物能够降解塑料,是因为微生物经过与塑料及类似物的长期共存,逐渐演化出一些能有效降解塑料的类群。孙超岷常常这样比喻:对于很多微生物而言,你给它吃面包、米饭,他们会活得很好,但如果它们没有那么好的生存环境,比如长期生活在塑料垃圾周围的微生物,为了生存,它们就会慢慢“进化”,通过分泌酶类“吃”塑料,获得额外的能量来源。
两周内即可将一些塑料降解为碎片
发现能“吃”塑料的海洋微生物,过程充满曲折。前两年,孙超岷团队的研究工作几乎没有任何进展。在发现能够分解塑料的海洋微生物菌群后,团队又耗时约3年,剔除菌群中不起降解作用的微生物,才获得精准有效的“吃”塑料微生物。“在这个筛选过程中,一遍遍重复失败,也曾想过放弃,庆幸的是最终坚持了下来。” 回顾多年来的科研经历,孙超岷团队成员、海洋所博士高蓉蓉不胜感慨。
其实,发现能有效降解塑料的海洋微生物已经是一个成果,但推动成果转化,他们还需要解决“降解速率”的现实问题。一般而言,微生物降解塑料是一个非常缓慢的过程,不会立竿见影——这也是国内外极少有课题组对此进行研究,即便研究目前也未取得突破性进展的原因。孙超岷团队此前的研究同样显示:发现的海洋微生物虽然能够降解塑料,但需要较长时间,甚至长达数月。
为攻克该难题,孙超岷团队加快实现能“吃”塑料海洋微生物的纯培养,即实现只在单一种类存在的状态下所进行的生物培养。“海洋中存在大量未知的微生物,我们团队的一项重要工作,就是基于采集的海洋样品,在实验室里实现未知海洋微生物的纯培养。海洋微生物若培养不出来,也就不可能了解它,更不可能利用它。” 孙超岷将他们海洋微生物的研究工作概括为 “三部曲”:培养、了解和利用。
简而言之,在发现能够分解塑料的“升级版”海洋微生物后,孙超岷团队首先实现了能“吃”塑料海洋微生物的纯培养,继而通过不断改良培养条件,让微生物加快分泌有利于降解塑料的酶种,如此大大提升了降解效率:一个月即可产生原来数月才能达到的降解效果,同时还拓宽了塑料降解谱,能够有效降解PP、PS、PVC、PUR等多种塑料。“对于PUR塑料和生物可降解塑料来说,第二天就可以看到穿透效果,约一周时间则可实现完全变形、酥脆,两周内将其降解为碎片。” 孙超岷表示。
推动从塑料降解到高值化生物转化
当前,“塑料污染已成为一种流行病。”联合国环境规划署提供的统计数据显示,世界塑料产量从1950年的200万吨飙升至2017年的3.48亿吨,预计到2040 年产能将翻一番。每年约有1100万吨塑料垃圾流入海洋。到2040年,这一数字可能会增加两倍。塑料生产和污染正对地球这个人类赖以生存的星球在气候变化、自然损失和污染方面造成“三重危机”并引发一场灾难。
从陆地到海洋,从最高的山峰到最深的海沟,塑料垃圾和污染已经无处不在。在今年3月份举行的第五届联合国环境大会续会上,来自175个国家的国家元首、环境部长和其他代表签署了《终止塑料污染决议(草案)》,旨在2024年前结束塑料污染,制定一项涉及塑料整个生命周期的具有法律约束力的国际协议,推动全球塑料污染治理。
应当看到,在塑料的生产、设计以及处理等方面,国内外都在积极进行探索,但垃圾处置目前仍缺少优异方案。“由于废旧塑料种类繁多、回收降解反应复杂,塑料垃圾中只有9%被回收,其余12%被焚烧,79%被填埋或者遗弃在了自然环境中。” 孙超岷说,塑料垃圾的处理方法主要有填埋、焚烧和利用微生物降解三种。只有微生物降解方式是绿色环保的,而该项研究还处于起步阶段,距离产业化应用仍有一段距离。
当前,孙超岷团队正在推动塑料降解方案“产业化”。这不仅是因为他们发现了能有效降解塑料的海洋微生物,同时研究还显示,今年发现的、经培养改良后的“吃”塑料海洋微生物不仅对环境无害,而且在降解塑料后其培养物能够产生有效抑制多种病原菌的活性物质。这意味着产业链上游可用于发展环境友好型塑料降解制品,下游生物基材料还可以用于生产抗生素等生物制品。
“我们正对该海洋微生物进一步培养优化,同时积极对接企业,努力实现对部分塑料(如聚酯型PUR)的工业级应用,建立‘从塑料降解到高值化生物转化’的一体化生物回收模式。”面对从“0”到“1”的课题,孙超岷也希望更多部门、企业、院校参与进来,加快从基础研究向实际应用转化,为我国塑料循环经济发展提供经济、环保、可行的“海洋方案”。
